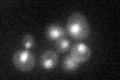
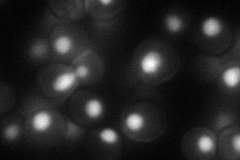
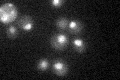

View description
Member of the NineTeen Complex (NTC) that contains Prp19p and stabilizes U6 snRNA in catalytic forms of the spliceosome containing U2, U5, and U6 snRNAs; binds directly to U6 snRNA; similar to S. pombe Cwf2
Localization:
Intensity:
Fold change:
Significance:
-
C’ GFP library in SD
nucleus24.91 -
N' NOP1pr-GFP in SD
nucleus51.8669 -
N' TEF2pr-mCherry in SD

nucleus54.2431 -
N' NATIVEpr-GFP in SD

nucleus22.8387 -
N' TEF2pr-VC and Cyto-VN in SD

nucleus35.1876 -
C’ GFP library in SD+DTT

nucleus23.550.94No -
C’ GFP library in SD+H2O2

nucleus22.270.89No -
C’ GFP library in Starvation Media
nucleus20.620.82No -
C’ GFP library on the background of Pup2-DaMP

nucleus -
C’ GFP library on the background of CCT mutant

nucleus25.75581.03379No
